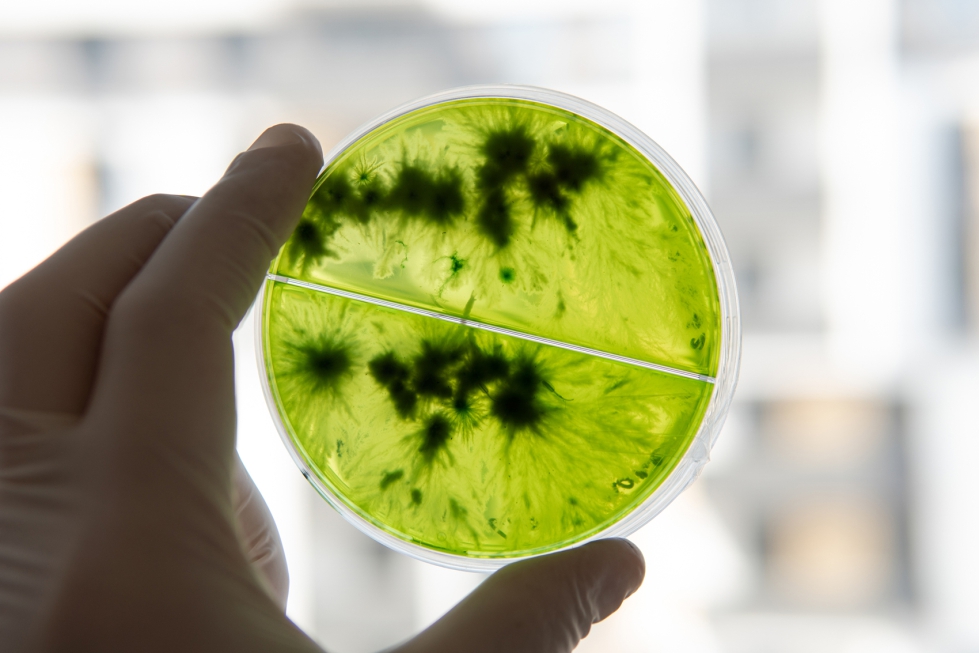
Los bioestimulantes articulan procesos fisiol�gicos y bioqu�micos de las plantas

La tendencia global de los bioestimulantes y agentes de biocontrol es de crecimiento significativo y sostenido en los últimos años
Desarrollo de biofertilizantes, bioestimulantes y agentes de biocontrol a partir de biorresiduos: una apuesta por la agricultura sostenible
Cristina Pérez Rivero, Jefa de Proyectos de Biotecnología Industrial.
Borja Villa Muñoz, Técnico de Biotecnología Industrial.
Rosa Doménech Mata, Gerente de Biotecnología Industrial.
04/06/2025El sector agrícola enfrenta el gran desafío de aumentar la productividad para alimentar a una población creciente sin deteriorar la salud del suelo ni repercutir en la calidad de los alimentos. Las consecuencias del cambio climático generan, además, nuevas fuentes de estrés para los cultivos: el aumento de temperaturas, períodos de sequía más intensos y prolongados, y condiciones de salinidad crecientes entre otros. Las temperaturas más altas, por ejemplo, producen un ambiente más propenso para la proliferación de insectos y hongos patógenos.
Esta necesidad de incrementar rendimientos y combatir plagas obliga a los agricultores a utilizar en mayor medida productos fertilizantes y pesticidas, desencadenando un impacto negativo en el medio ambiente. Estos desafíos exigen un replanteamiento de los modelos de agricultura tradicionales y una transición hacia modelos ecológicos y respetuosos con el medio ambiente. La agricultura sostenible apuesta así por promover ecosistemas saludables y realizar una gestión adecuada de la tierra, agua y recursos naturales, en línea con los principios de economía circular.

El Pacto Verde Europeo (European Green Deal) y, dentro de él, la estrategia De la Granja a la Mesa (Farm to Fork), lanzados por la Comisión Europea, establecen objetivos muy claros para dirigir la transición hacia una agricultura más sostenible, como, por ejemplo:
- Reducir el uso de plaguicidas químicos en un 50% para 2030.
- Reducir en al menos un 20% el uso de fertilizantes minerales (nitrógeno y fósforo) para 2030, mejorando su eficiencia de uso y disminuyendo la contaminación por nutrientes que provocan.
- Alcanzar un 25% de la superficie agrícola de la UE dedicada a agricultura ecológica para 2030.
Dichas regulaciones impactan directamente en el desarrollo y adopción de nuevos productos biofertilizantes, bioestimulantes y agentes de biocontrol en agricultura. Además, ponen de manifiesto la apuesta de la Unión Europea por una transición agroecológica en la que los productos biobasados y la biotecnología como medio de producción se conviertan en herramientas estratégicas para reducir los insumos químicos y aumentar la biodiversidad y resiliencia agrícola.
Biofertilizantes, bioestimulantes y agentes de biocontrol
Los biofertilizantes son productos elaborados sobre la base de restos vegetales, bacterias, hongos y microorganismos, utilizados en la fertilización y nutrición vegetal. Los bioestimulantes, hoy en día, están englobados dentro de los productos fertilizantes. Estos se definen, según el Reglamento (UE) 2019/1009 sobre productos fertilizantes, como sustancias y/o microorganismos cuya función es la de estimular los procesos naturales que mejoren o beneficien la absorción de nutrientes, la eficiencia de estos, la tolerancia al estrés abiótico y la calidad del cultivo.

Cada producto bioestimulante puede estar formulado de forma diferente para provocar efectos diversos en los cultivos, según las necesidades concretas de determinado productor. Algunas de las principales funciones de los bioestimulantes son la mejora de la eficiencia en el uso y asimilación de los nutrientes, el incremento de la tolerancia de los cultivos al estrés abiótico, la mejora de la calidad de los cultivos, y la mejora la disponibilidad de los nutrientes insolubles en el suelo.
En concreto, los agentes bioestimulantes pueden tener una o varias de las siguientes actividades:
- Participación en la fijación biológica del nitrógeno atmosférico en formas asimilables para las plantas.
- Aumento de la biodisponibilidad del fósforo (solubilización) para su uso por las plantas.
- Producción de sideróforos que quelatan el ion Fe3+ presente en el suelo e inaccesible a la planta por su carácter insoluble.
- Descomposición y mineralización de la materia orgánica del suelo.
- Liberación de sustancias biológicamente activas como fitohormonas (auxinas, citoquininas, giberelinas) o enzimas que estimulan el desarrollo vegetal.
- Incremento de la eficiencia del sistema radicular para absorber nutrientes.
De esta forma los bioestimulantes, sin hacer un aporte directo de nutrientes, reducen la necesidad de suplementación con fertilizantes. Existen distintos tipos de bioestimulantes: ácidos húmicos y fúlvicos, aminoácidos y mezclas de péptidos, extractos de algas y plantas, hongos, bacterias, quitosanos y otros biopolímeros, y compuestos inorgánicos.
Por su parte, cuando hablamos de agentes de biocontrol (biopesticidas) nos referimos a materiales naturales -como plantas, bacterias y ciertos minerales- que mejoran la resistencia al estrés biótico de las plantas. Los agentes de biocontrol pueden ejercer una acción directa o indirecta para combatir los organismos patógenos que afectan a las plantas. Así, pueden inhibir directamente el crecimiento del patógeno mediante la competencia por los recursos, la producción de compuestos antimicrobianos (antibiosis), parasitando o consumiendo directamente al patógeno.
Además, los agentes de biocontrol pueden afectar indirectamente a los patógenos desencadenando respuestas de defensa de las plantas, haciéndolas más resistentes a la infección. Entre los agentes de biocontrol encontramos inductores de defensas como los elicitores bacterianos y fúngicos, los microorganismos antagonistas, bacteriófagos y endolisinas.

La aplicación de productos bioestimulantes puede ser foliar mediante pulverización o agua de riego.
Producción a partir de biorresiduos
Una estrategia que permite la transición hacia modelos sostenibles de agricultura a la vez que resuelve el problema de la gestión de los residuos agrícolas, es su valorización para la producción de bioestimulantes y agentes de biocontrol. Los residuos orgánicos derivados de la actividad agrícola (restos de poda, destríos, rastrojos, etc.) son una fuente de nutrientes y compuestos bioactivos que pueden ser utilizados como medio de cultivo para el crecimiento de microorganismos o para la extracción de sustancias con actividad bioestimulante o biocontrol (p. ej. extractos botánicos ricos en polifenoles, ácidos orgánicos, péptidos, terpenoides, taninos, compuestos fenólicos, alcaloides ).
Este modelo productivo nos acerca a los planteamientos de circularidad y 'residuo cero' acordados en los planes de acción europeos, donde los propios residuos de cultivo pueden servir para generar agentes de bioestimulación y biocontrol aplicables a los mismos cultivos.

Regulación y mercado
Los productos fertilizantes están regulados en la Unión Europea según el Reglamento 2019/1009, que autoriza una serie de microorganismos como productos biofertilizantes: hongos micorrícicos, Azotobacter spp., Rhizobium spp., Azospirillum spp. Además, dentro de otras categorías menores, en el caso de la normativa nacional española el Grupo 4 'Otros abonos productos especiales' permite el registro de producto a base de microorganismos micorrizas, no micorrícicos y mezclas.
Actualmente, existen en el mercado una gran variedad de productos que contienen entre sus ingredientes algún microorganismo o derivado (e.g. Bacillus thuringiensis, B. subtillis, Pseudomonas fluorescenes, Spirulina patensis, Trichoderma spp., Chlorella spp.), y existen multitud de solicitudes en proceso de evaluación que permitirán aumentar el listado de bioagentes.
Cabe destacar que los agentes de biocontrol se rigen por el Reglamento (CE) 1107/2009 sobre productos fitosanitarios y posteriores modificaciones. Normalmente, el proceso para el registro de un nuevo producto es más largo que el de un bioestimulante y exige mayores requisitos documentales. Además, todo agente de biocontrol que se comercialice en España ha de estar inscrito en el Registro Fitosanitario del MAPA.

La tendencia global de los bioestimulantes y agentes de biocontrol es de crecimiento significativo y sostenido en los últimos años. La Tasa de Crecimiento Anual Compuesta o CAGR (del inglés Compound Annual Growht Rate) de los biopesticidas en el período de 2024 a 2031 es del 15,2%. Esta subida está motivada por una demanda creciente de alimentos orgánicos.
Sin embargo, aún existen frenos ante la adopción generalizada de los mismos por una falta de datos consistentes y homogéneos. Es imperante, por tanto, que continúe la actividad de I+D en torno a los mecanismos de acción, formulación (colonización de la planta), dosis, y de aplicación de los nuevos desarrollos para conseguir que los ensayos in vitro sean traslados con éxito a ensayos de campo.

En conclusión, el aprovechamiento de biorresiduos para el desarrollo de biofertilizantes, bioestimulantes y agentes de biocontrol representa una estrategia integral que conecta la sostenibilidad agrícola con la economía circular. Estos productos, obtenidos a partir de residuos orgánicos valorizados mediante procesos biotecnológicos, no solo permiten reducir la dependencia de insumos de síntesis química, sino que además mejoran la salud del suelo, estimulan el crecimiento vegetal y fortalecen la resistencia natural de los cultivos frente a estreses bióticos y abióticos.
Este enfoque innovador se está consolidando como una vía clave para transformar los desafíos ambientales y económicos del sector agrícola en oportunidades reales de innovación. El impulso a este tipo de soluciones naturales contribuye a una agricultura más resiliente, productiva y respetuosa con el entorno, alineada con los objetivos europeos de sostenibilidad y neutralidad climática.
Los residuos orgánicos derivados de la actividad agrícola (restos de poda, destríos, rastrojos, etc.) son una fuente de nutrientes y compuestos bioactivos



























